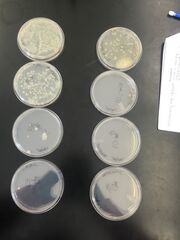

Uploads by Lynda Gabriela Arostegui
From OpenWetWare
Jump to navigationJump to search
This special page shows all uploaded files.
| Date | Name | Thumbnail | Size | Description |
|---|---|---|---|---|
| 13:08, 17 March 2016 | Screen Shot 2016-03-17 at 9.07.05 AM.png (file) |  |
32 KB | |
| 13:08, 17 March 2016 | 2 ZEBRAFISH.png (file) |  |
31 KB | |
| 02:42, 11 February 2016 | LG final plant sample.JPG (file) |  |
1.22 MB | |
| 02:14, 11 February 2016 | LG sample four underside.JPG (file) |  |
1.28 MB | |
| 02:13, 11 February 2016 | LG fourth sample.JPG (file) |  |
1.24 MB | |
| 01:49, 11 February 2016 | LG lettuce sample vascularity.JPG (file) |  |
1.86 MB | |
| 01:46, 11 February 2016 | LG lettuce whoel sample.JPG (file) |  |
1.45 MB | |
| 01:46, 11 February 2016 | Lettuce whole sample.JPG (file) |  |
1.45 MB | |
| 00:30, 11 February 2016 | LG sample two vascularity.JPG (file) |  |
1.49 MB | |
| 00:17, 11 February 2016 | LG sample two plant.JPG (file) |  |
1.47 MB | |
| 00:10, 11 February 2016 | LG first plant sample vascularity.JPG (file) |  |
1.18 MB | |
| 00:04, 11 February 2016 | LG first plant sample.JPG (file) |  |
1.19 MB | |
| 00:00, 11 February 2016 | LG pano of transect 5.jpeg (file) |  |
6.19 MB | |
| 23:50, 3 February 2016 | Lynda Arostegui before gram.png (file) |  |
771 KB | |
| 23:49, 3 February 2016 | Lynda Arostegui pos gram.JPG (file) |  |
1.88 MB | |
| 01:28, 1 February 2016 | Colonies chart.jpg (file) |  |
670 KB | |
| 01:26, 1 February 2016 | -tet from hay infusion.JPG (file) | |
1.6 MB | |
| 02:14, 28 January 2016 | Lynda Arostegui organism found lab 2.JPG (file) |  |
1.48 MB | |
| 01:31, 28 January 2016 | Lynda Arostegui serial dilution.JPG (file) |  |
1.41 MB | |
| 01:30, 28 January 2016 | Lynda Arostegui Hay Infusion top.JPG (file) |  |
1.64 MB | |
| 01:30, 28 January 2016 | Lynda Arostegui Hay Infusion side.JPG (file) |  |
1.52 MB | |
| 01:10, 28 January 2016 | Lynda Arostegui lab 1 drawing.JPG (file) |  |
1.75 MB | |
| 20:58, 20 January 2016 | IMG 3795.JPG (file) |  |
1.75 MB | Transect #5 is located on the northern east side of the American University campus, along side the tennis courts. This transect is a fenced in community garden that contains a variety of different vegetables like lettuce and carrots throughout the garden. |